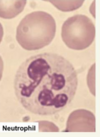

what faci
Define Haematocrit (PCV)
ratio of volume of red blood cells to total volume (45%)
Define Haemopoiesis
formation of new blood cells and platelets
Define Anaemia
reduced haemoglobin or numbers of RBCs, often
due to iron deficiency
Define Haemostasis
the arrest of bleeding, involving blood coagulation and the contraction of damaged blood vessels.
1. vascular spasm
2. Primary- forms temporary platelet plug
3. Secondary- coagulation cascade forms permanent fibrin clot
Summarise how a platelet plug is formed
- Vessel damage and vWF secretion by endothelial cells
- vWF binds (adheses) platelets to exposed collagen in damaged vessel wall
- Platelet Activation: shape change and fibrinogen receptors (GPIIb/IIIa) expressed
- Secretions: alpha granules and dense granules
- Fibrinogen from liver binds to receptors on platelets = Aggregation

draw out the coagulation cascade on a whiteboard.
what is made by the liver?
what are witamin K dependent?
Liver makes all except VIII
Vit K dependent: X, IX, VII, II (thrombin)

what secreted von Willebrand factor?
what does it do?
endodthelial cells.
vWF bunds to exposed collagen which allows platelets to bind to collagen via (GP1B receptors)

What do alpha granules secrete?
alpha granules secreted by activated, anchored platelets
more vWF - platelet adherence and activation
PlateletDerivedGrowthFactor (PDGF) = assists in long term wound healing

what do dense granules secrete?
from activates, anchored platelets
Adenosine diphosphate (ADP) - binds to P2y12
Thromboxane (TXA2) - binds to TP
both promote more platelet activation

what enzyme promotes the synthesis of Thromboxane?
Cyclooxygenase (COX) and thromboxane synthase
Define Haemophillia
inability to make blood clots due to factor VIII
deficiency (Haemophilia A) or factor IX deficiency (Haemophilia B – Christmas disease). (Haemophilia A is more common.)
In adults, where are precursors of mature blood cells derived from?
Bone marrow of axial skeleton.
(all bones in children)
In embryos, where are the precursors of mature blood cells derived from?
yolk sac, liver, spleen bone marrow.
What is the production of RBCs called?
what is the hormone stimulating factor?
When is this hormone released?
Production = Erythropoiesis
Hormone = Erthyropoietin (EPO)
Released: low level continuously and in response to hypoxia
What is the production of WBCs called?
What is the hormone factor?
Production = myelopoiesis
Hormone factor=granulocyte-macrophege colony stimulating factor (GMCSF)
only stimulates myeloblastic WBCs not lymphoid cells
What is the production of platelets called?
What is the hormonal factor?
How does it work?
Thrombopoiesis
Hormonal factor = Thrombopoietin
works by increasing production of megakaryocytes which platelets bud off from.
what is the lifespan of an erythrocyte?
120 days
where are RBCs removed?
the reticuloendothelial system (spleen, liver, bonemarrow)
and blood loss
where is haemoglobin found?
in Erthythrocytes
describe the structure of haemoglobin
Tetrameric protein with 4 globin chains, each with a haem group with central ferrous iron. Capable of reversibly binding to oxygen.
HbA = 2 alpha chains 2 beta chains

Describe the structure of HbF
2alpha chains, 2 gamma chains
What levels of haemoglobin would count as anaemic
Male < 130g/L
Female <110g/L
Signs and symptoms of anaemia
pallor, tachycardia,
hyperventilation on exertion, malaise and angina